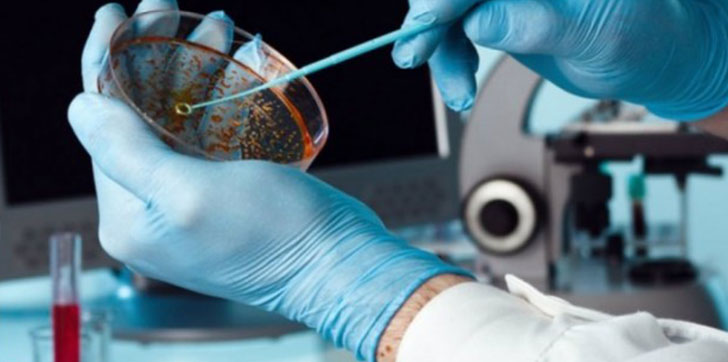
investigadores-moleculas

Investigadores encuentran en RD moléculas anticancerígenas
Un equipo de investigadores de la Universidad Autónoma de Santo Domingo (UASD) encontró en República Dominicana una planta que posee moléculas anticancerígenas de alto nivel y cuyo descubrimiento pondría bien en alto el nombre nuestro país.
El grupo de expertos, integrado por profesores de química y encabezado por el doctor Quírico Castillo, ya dio los pasos ante la Oficina Nacional de la Propiedad Intelectual (ONAPI) para registrar la autoría de ese hallazgo, que podría evitar la muerte de millones de personas en todo el mundo.
Castillo explicó que esas moléculas podrían ayudar a la ciencia médica en su carrera por combatir los cánceres de mama, riñones, cérvix, próstata, pulmón, el colón y la piel.
De acuerdo con el reputado facultativo, la planta encontrada y que ha sido estudiada profundamente es de la familia perteneciente a la Asteraceae y es nativa de nuestro país.
“Queremos informar, con gran entusiasmo y orgullo, que nuestro equipo de investigación ha solicitado la patente de invención ante la ONAPI de una nueva especie endémica de la isla”, puntualizó Castillo.
También señaló que las moléculas son unas lactonas sesquiter penicas tipo germacranólido y presentan muy buena actividad anti cáncer en todas las líneas celulares ensayadas.
Asimismo, comunicó que los estudios muestran que ese árbol posee sustancias de alto nivel capaces de enfrentar el cáncer, pero que por medidas de seguridad autoral no revelarán ahora el nombre de la especie ni sus estructuras químicas.
El investigador uasdiano dio estas informaciones al ofrecer una conferencia organizada por la Facultad de Ciencias de esa casa de altos estudios, con motivo de la celebración de su fundación, que tuvo lugar en el 1966.
Durante su disertación, resaltó que las indagaciones están refrendadas por expertos internacionales, entre ellos el doctor José Manuel Padrón, de España, quien es un respetado farmacéutico y poseedor de un PHD en esa rama científica.
Igualmente, mencionó a la licenciada en Farmacia Evelyn Almánzar, de República Dominicana, el cristalógrafo Lukasz Wojtas, de la Universidad del Sur de La Florida, y del doctor Mehdi Keramane, catedrático de la Universidad McMaster de Canadá.






